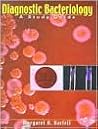
Diagnostic Bacter...

our children live or die with or without us. No matter what we do, no matter how we agonize or obsess, we cannot choose for our children whether they live or die. It is a devastating realization, but also liberating. I finally chose life
...more
Erica’s 2025 Year in Books
Take a look at Erica’s Year in Books, including some fun facts about their reading.
Favorite Genres
Polls voted on by Erica
Lists liked by Erica